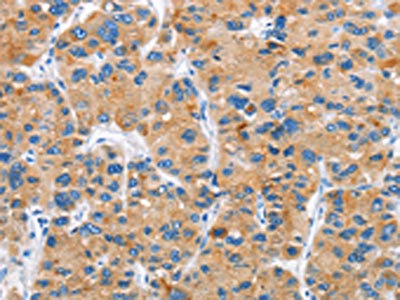

DKK2 Antibody
-
中文名稱:DKK2兔多克隆抗體
-
貨號(hào):CSB-PA694579
-
規(guī)格:¥1100
-
圖片:
-
其他:
產(chǎn)品詳情
-
Uniprot No.:
-
基因名:
-
別名:Dickkopf 2 antibody; Dickkopf gene 2 antibody; Dickkopf homolog 2 antibody; Dickkopf related protein 2 antibody; Dickkopf WNT signaling pathway inhibitor 2 antibody; Dickkopf-2 antibody; Dickkopf-related protein 2 antibody; Dickkopf2 antibody; DKK 2 antibody; Dkk-2 antibody; Dkk2 antibody; DKK2_HUMAN antibody; hDkk 2 antibody; hDkk-2 antibody; hDkk2 antibody
-
宿主:Rabbit
-
反應(yīng)種屬:Human,Mouse
-
免疫原:Fusion protein of Human DKK2
-
免疫原種屬:Homo sapiens (Human)
-
標(biāo)記方式:Non-conjugated
-
抗體亞型:IgG
-
純化方式:Antigen affinity purification
-
濃度:It differs from different batches. Please contact us to confirm it.
-
保存緩沖液:-20°C, pH7.4 PBS, 0.05% NaN3, 40% Glycerol
-
產(chǎn)品提供形式:Liquid
-
應(yīng)用范圍:ELISA,IHC
-
推薦稀釋比:
Application Recommended Dilution ELISA 1:2000-1:5000 IHC 1:50-1:200 -
Protocols:
-
儲(chǔ)存條件:Upon receipt, store at -20°C or -80°C. Avoid repeated freeze.
-
貨期:Basically, we can dispatch the products out in 1-3 working days after receiving your orders. Delivery time maybe differs from different purchasing way or location, please kindly consult your local distributors for specific delivery time.
-
用途:For Research Use Only. Not for use in diagnostic or therapeutic procedures.
相關(guān)產(chǎn)品
靶點(diǎn)詳情
-
功能:Antagonizes canonical Wnt signaling by inhibiting LRP5/6 interaction with Wnt and by forming a ternary complex with the transmembrane protein KREMEN that promotes internalization of LRP5/6. DKKs play an important role in vertebrate development, where they locally inhibit Wnt regulated processes such as antero-posterior axial patterning, limb development, somitogenesis and eye formation. In the adult, Dkks are implicated in bone formation and bone disease, cancer and Alzheimer disease.
-
基因功能參考文獻(xiàn):
- our findings demonstrate that DKK2 functions as a tumor suppressor through inhibiting cell proliferation and inducing apoptosis via regulating Wnt signaling during breast tumorigenesis. PMID: 28467796
- Knock down of the dickkopf WNT signaling pathway inhibitor 2 (DKK2) resulted in a significant suppression of HOXD10, HOXD11 and HOXD13 while over-expression of DKK2 and stimulation with factors of the WNT signaling pathway. PMID: 27363011
- epigenetic silencing of Wnt antagonists was associated with gastric carcinogenesis, and concurrent hypermethylation of SFRP2 and DKK2 could be a potential marker for a prognosis of poor overall survival. PMID: 28152305
- the genotyping and functional findings are consistent with the hypothesis that DKK2 is a tumor suppressor; by selectively retaining a transcriptionally inactive DKK2 allele, the reduction of DKK2 function results in unchecked Wnt/beta-catenin signaling, contributing to hepatocellular carcinoma oncogenesis. PMID: 27203079
- The present report suggested that DKK2 downregulation suppressed the proliferation and invasion of prostate cancer cells by inhibiting the Wnt/betacatenin signaling pathway. PMID: 27431620
- these findings reveal that the miR-187-5p-DKK2 pathway regulates Wnt/beta-catenin signaling, cell growth, and apoptosis. Our findings provide the first evidence of a role for miR-187-5p in promotion of B-cell ALL. PMID: 27296949
- Genetic variant in DKK2 gene is associated with gallbladder cancer. PMID: 26715268
- targeting of DKK2 by miR-154 leads to upregulation of beta-catenin expression and activation of the classical Wnt signaling pathway and cardiac fibroblasts. PMID: 27542661
- MiR-21 overexpression was significantly correlated with the DKK2-/beta-catenin- immunohistochemical phenotype. PMID: 23999978
- Data indicate that inhibiting dickkopf-related protein 2 (DKK2)with siDKK2 reduced the expression of DKK2, but had no effect on leptin expression. PMID: 25312721
- We found 1 DKK2 SNP to be significantly associated with alcohol-related harm in alcoholic subjects PMID: 24117450
- a new regulatory mechanism of miR-222 PMID: 23587485
- Our results provide strong evidence that DKK2 is a key player in Ewing sarcoma invasion and osteolysis and also in the differential phenotype of Ewing sarcoma cells. PMID: 23204234
- DKK2 may contribute to tumorigenesis in epithelial ovarian cancer(EOC) through the Wnt/beta-catenin signaling mechanisms. PMID: 22964660
- Elevated TGF-beta1 levels in osteoarthritic osteoblasts can stimulate DKK2 expression. PMID: 21312269
- In the study of the genetics of alcoholism, three SNPs in DKK2 (rs427983; rs419558; rs399087) demonstrated empirical significance. PMID: 20332099
- DKK2 is epigenetically silenced by methylation in higher grades and stages of renal cell carcinoma; results suggest that DKK2 inhibits renal cancer progression through apoptotic and cell cycle pathways PMID: 19755393
- Analysis of individual Dkk domains and chimeric Dkks shows that the carboxy-terminal domains of both Dkk1 & 2 associate with LRP6 and are necessary and sufficient for Wnt8 inhibition. PMID: 12167704
- analysis of the structural basis of the interaction between Dkk and low density lipoprotein receptor-related protein (LRP) 5/6 PMID: 18524778
顯示更多
收起更多
-
亞細(xì)胞定位:Secreted.
-
蛋白家族:Dickkopf family
-
組織特異性:Expressed in heart, brain, skeletal muscle and lung.
-
數(shù)據(jù)庫鏈接:
Most popular with customers
-
-
YWHAB Recombinant Monoclonal Antibody
Applications: ELISA, WB, IHC, IF, FC
Species Reactivity: Human, Mouse, Rat
-
Phospho-YAP1 (S127) Recombinant Monoclonal Antibody
Applications: ELISA, WB, IHC
Species Reactivity: Human
-
-
-
-
-